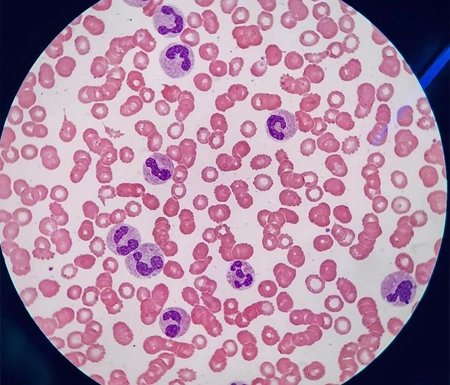
laboix
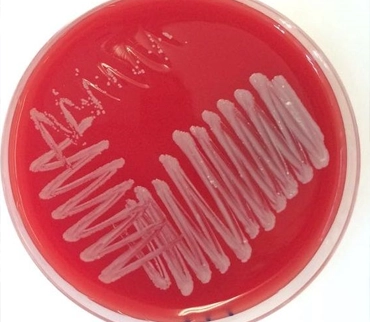
Microbiología

SOBRE NOSOTROS
Servicios clínicos de alta calidad, accesibles y confiables
Laboratorio Clínico Valenzuela es un centro dedicado al diagnóstico clínico con presencia en Ciudad de Guatemala (Zona 7) y Villa Nueva.
Misión
Aspiramos a crecer de forma constante, incorporando innovación tecnológica y formación continua.
- Comprometidos con el medio ambiente
- Equipo altamente capacitado y experimentado
- 40 años de trayectoria profesional comprobada
NUESTROS SERVICIOS
Ofrecemos soluciones personalizadas
para tu bienestar
POR QUÉ ELEGIRNOS
Un laboratorio de confianza con amplia trayectoria
Más de 40 años entregando resultados confiables, atención humana y compromiso con la calidad.

Diagnósticos precisos
Realizamos análisis clínicos precisos para apoyar un diagnóstico confiable.

Tecnología avanzada
Contamos con equipos avanzados que garantizan resultados precisos.

OPINIONES
Esto dicen sobre nosotros...
Además de la puntualidad, me explicaron cada detalle con mucha paciencia. Un servicio confiable y de calidad.
La atención al cliente es excelente. Me ofrecieron la opción de recibir mis resultados en línea, lo cual me ahorró mucho tiempo. La experiencia fue cómoda y profesional en todo momento.
Me sentí en buenas manos en todo momento.
Me recomendaron este laboratorio para mis análisis de orina y estoy muy contento con el trato recibido.
El personal es muy amable y los resultados me los entregaron rápido y de forma clara. Sin duda los recomiendo.

Comprometidos con el medio ambiente
Contamos con licencia ambiental desde el 2018. Adoptamos prácticas sostenibles que minimizan el impacto ambiental de nuestras actividades, promoviendo una cultura de respeto y conciencia ecológica.
SU MEJOR OPCIÓN
Somos miembros y participamos en programas de control de calidad externa.